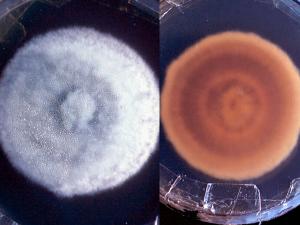
Culture of Coccidioides immitis showing a suede-like to downy, greyish white colony with a tan to brown reverse.

Dimorphic Systemic Mycoses
These are fungal infections of the body caused by fungal pathogens which can overcome the physiological and cellular defences of the normal human host by changing their morphological form. They are geographically restricted and the primary site of infection is usually pulmonary, following the inhalation of conidia.
| Disease | Causative organisms | Incidence |
|---|---|---|
| Blastomycosis | Blastomyces dermatitidis | Rare* |
| Coccidioidomycosis | Coccidioides immitis/posadasii | Rare* |
| Histoplasmosis | Histoplasma capsulatum | Rare* |
| Paracoccidioidomycosis | Paracoccidioides brasiliensis/lutzii | Rare* |
| Talaromyces marneffei infection | Talaromyces marneffei | Rare* |
| *more common in endemic areas. | ||
Histopathology is especially useful and is one of the most important ways of alerting the laboratory that they may be dealing with a potential pathogen.
| Mycoses | Tissue morphology |
|---|---|
| Blastomycosis | Large broad base unipolar budding yeast cells (8-10um). |
| Coccidioidomycosis | Spherules (10-80um) with endospores (2-5um). |
| Histoplasmosis | Small narrow base budding yeast cells (1-5um; 5-2um in var. duboisii) |
| Paracoccidioidomycosis | Large narrow base, multi-budding yeast cells (20-60um). |
| Talaromyces marneffei | Small, oval to ellipsoidal yeast-like cells (3 µm in diameter). |
| Sporotrichosis | Small narrow base budding yeast cells (2-5um). |
WARNING: Cultures of Blastomyces dermatitidis, Coccidioides immitis, Histoplasma capsulatum and Talaromyces marneffei represent a severe biohazard to laboratory personnel and must be handled with extreme caution in an appropriate pathogen handling cabinet.
In the past microscopic morphology, conversion from the mould form to the yeast or spherule form, and animal pathogenicity have all been used; however culture identification by either exoantigen test or DNA sequencing is now preferred to minimise exposure to the infectious propagules.
Mycoses descriptions
-
Blastomycosis
Blastomycosis is a chronic granulomatous and suppurative disease having a primary pulmonary stage that is frequently followed by dissemination to other body sites, chiefly the skin and bone. Although the disease was long thought to be restricted to the North American continent, in recent years autochthonous cases have been diagnosed in Africa, Asia and Europe. All available clinical and epidemiological evidence indicates that humans and lower animals contract blastomycosis from some source in nature. However, the natural habitat of B. dermatitidis has yet to be clearly delineated, despite some reports of its isolation from soil.
Clinical manifestations:
Pulmonary blastomycosis: In most individuals pulmonary lesions are asymptomatic and are not detected until the infection has spread to other organs. Others develop symptoms after an incubation period of 3-15 weeks. In most cases blastomycosis is indolent in onset and patients present with chronic symptoms such as cough, fever, malaise and weight loss. The lesions become more extensive, with continued suppuration and eventual necrosis and cavitation. Occasional patients present with an acute onset of infection, with development of high fever, chills, productive cough, myalgia, arthralgia and pleuritic chest pain. Often these patient appear to recover after 2-12 weeks of symptoms, but some will return months later with lesions at other sites. Other patients with acute onset will fail to recover and will develop a chronic chest infection or disseminated infection. Chest radiographic findings are variable and are not diagnostic.
Cutaneous blastomycosis: Haematogenous spread gives rise to cutaneous lesions in over 70% of patients. These tend to be painless and present either as raised verrucous lesions with irregular borders, or as ulcers. The face, upper limbs, neck and scalp are the most frequent sites involved.
Click images below to expand:
Osteoarticular blastomycosis: Occurs in about 30% of patients with the spine, pelvis, cranial bones, ribs and long bones most commonly involved. Patients often remain asymptomatic until the infection spreads into contiguous joints, or into adjacent soft tissue causing subcutaneous abscesses. Radiological findings are often non-specific and arthritis occurs in up to 10% of patients.
Other forms include genitourinary blastomycosis involving the prostrate, epididymis or testis; haematogenous spread to the brain causing meningitis, and spinal or brain abscess. Other organs may also be involved and choroiditis and endophthalmitis have been reported.
AIDS patient have developed fulminant blastomycosis with widespread dissemination following endogenous reactivation of previous infection.
Laboratory diagnosis:
Clinical material:
Skin scrapings, sputum and bronchial washings, cerebrospinal fluid, pleural fluid and blood, bone marrow, urine and tissue biopsies from various visceral organs.
Tissue sections showing large, broad-base, unipolar budding yeast-like cells, 8-15 um in diameter.
Direct microscopy:
(a) Skin scrapings should be examined using 10% KOH and Parker ink or calcofluor white mounts; (b) Exudates and body fluids should be centrifuged and the sediment examined using either 10% KOH and Parker ink or calcofluor white mounts, (c) Tissue sections should be stained using PAS digest, Grocott's methenamine silver (GMS) or Gram stain.Histopathology is especially useful and is one of the most important ways of alerting the laboratory that they may be dealing with a potential pathogen.
Note: Tissue sections need to be stained by Grocott's methenamine silver method to clearly see the yeast-like cells, which are often difficult to observe in H&E preparations.
Interpretation:
As a rule, a positive direct microscopy demonstrating characteristic yeast-like cells from any specimen should be considered significant.Culture:
Clinical specimens should be inoculated onto primary isolation media, like Sabouraud's dextrose agar and Brain heart infusion agar supplemented with 5% sheep blood.Interpretation:
A positive culture from any of the above specimens should be considered significant.WARNING:
Cultures of Blastomyces dermatitidis represent a severe biohazard to laboratory personnel and must be handled with extreme caution in an appropriate pathogen handling cabinet.Serology:
Serological tests are of limited value in the diagnosis of Blastomycosis.Identification:
In the past microscopic morphology, conversion from the mould form to the yeast form, and animal pathogenicity have all been used; however however culture identification by either exoantigen test or DNA sequencing is now preferred to minimise exposure to the infectious propagules.Causative agents:
Blastomyces dermatitidisFurther reading:
Ajello L and R.J. Hay. 1997. Medical Mycology Vol 4 Topley & Wilson's Microbiology and Infectious Infections. 9th Edition, Arnold London.Howard, DH (ed) 1983-1985.
Kwon-Chung KJ and JE Bennett 1992. Medical Mycology Lea & Febiger.
Richardson MD and DW Warnock. 1993. Fungal Infection: Diagnosis and Management. Blackwell Scientific Publications, London.
Rippon JW. 1988. Medical Mycology WB Saunders Co -
Coccidioidomycosis
Coccidioidomycosis is initially, a respiratory infection, resulting from the inhalation of conidia, that typically resolves rapidly leaving the patient with a strong specific immunity to re-infection. However, in some individuals the disease may progress to a chronic pulmonary condition or to a systemic disease involving the meninges, bones, joints and subcutaneous and cutaneous tissues. Coccidioides immitis is a soil inhabiting fungus endemic in south-western U.S.A., northern Mexico and various centres in South America. Several cases have now been diagnosed in Australia, all in patients with a history of travel to endemic areas.
Clinical manifestations:
60% of individuals suffer a benign and transient chest infection that does not require medical attention. Of the 40% who develop symptoms, most will have an acute febrile "flu-like" illness starting 7-28 days (average 10-16 days) after exposure and most patients will recover completely. The main symptoms are fever, pleuritic chest pain, cough, malaise, headache, myalgia, night sweats and loss of appetite. Many patients also develop a mild, diffuse erythematous or maculopapular rash on the trunk and limbs. However, 5-10% of patients that do develop symptoms are left with pulmonary residual nodule or cavity that is usually detected several months or years later. Another 5% of patients may develop metapulmonary dissemination to the meninges, bones, joints and subcutaneous and cutaneous tissues, within the first few weeks to months after the onset of primary infection .
Click images below to expand:
Clinical material:
Skin scrapings, sputum and bronchial washings, cerebrospinal fluid, pleural fluid and blood, bone marrow, urine and tissue biopsies from various visceral organs.Direct microscopy:
(a) Skin scrapings should be examined using 10% KOH and Parker ink or calcofluor white mounts; (b) Exudates and body fluids should be centrifuged and the sediment examined using either 10% KOH and Parker ink or calcofluor white mounts, (c) Tissue sections should be stained using PAS digest, Grocott's methenamine silver (GMS) or Gram stain.Histopathology is especially useful and is one of the most important ways of alerting the laboratory that they may be dealing with a potential pathogen.
Interpretation:
As a rule, a positive direct microscopy demonstrating spherules (10-80um) with endospores (2-5um) from any specimen should be considered significant.Click images below to expand:
Culture:
Clinical specimens should be inoculated onto primary isolation media, like Sabouraud's dextrose agar and Brain heart infusion agar supplemented with 5% sheep blood.Interpretation:
A positive culture from any of the above specimens should be considered significant.WARNING:
Cultures of Coccidioides immitis represent a severe biohazard to laboratory personnel and must be handled with extreme caution in an appropriate pathogen handling cabinet. .Serology:
Immunodiffusion and/or complement fixation tests for the detection of antibody have proven to be useful in the diagnosis of Coccidioidomycosis especially in immunocompetent patients. However, detection of antibodies in immunosuppressed patients is often difficult, with between 20-50% of patients testing negative.Identification:
In the past microscopic morphology, conversion from the mould form to the yeast or spherule form, and animal pathogenicity have all been used; however however culture identification by either exoantigen test or DNA sequencing is now preferred to minimise exposure to the infectious propagules.Causative agents:
Coccidioides immitisFurther reading:
Ajello L and R.J. Hay. 1997. Medical Mycology Vol 4 Topley & Wilson's Microbiology and Infectious Infections. 9th Edition, Arnold London.
Chandler FW., W. Kaplan and L. Ajello. 1980. A colour atlas and textbook of the histopathology of mycotic diseases. Wolfe Medical Publications Ltd. London.
Kwon-Chung KJ and JE Bennett 1992. Medical Mycology Lea & Febiger.
Richardson MD and DW Warnock. 1993. Fungal Infection: Diagnosis and Management. Blackwell Scientific Publications, London. -
Histoplasmosis
Histoplasmosis is an intracellular mycotic infection of the reticuloendothelial system caused by the inhalation of conidia from the fungus Histoplasma capsulatum. Histoplasmosis has a world wide distribution, however, the Mississippi-Ohio River Valley in the U.S.A. is recognized as a major endemic region. Africa, Australia and parts of East Asia, in particular India and Malaysia are also endemic regions.
Environmental isolations of the fungus have been made from soil enriched with excreta from chicken, starlings and bats. Three varieties of Histoplasma capsulatum are recognised, depending on the clinical disease: var.capsulatum is the common cause of histoplasmosis; var. duboisii is the African type and var. farciminosum causes lymphangitis in horses. Histoplasma isolates may also resemble species of Sepedonium and Chrysosporium. Traditionally, positive identification required conversion of the mould form to the yeast phase by growth at 37C on enriched media, however for laboratory safety, culture identification by either exoantigen test or DNA sequencing is now preferred.

Histoplasmosis of the lower gum showing ulcer around base of the teeth.
Clinical manifestations:
Approximately 95% of cases of histoplasmosis are inapparent, subclinical or benign. Five percent of the cases have chronic progressive lung disease, chronic cutaneous or systemic disease or an acute fulminating fatal systemic disease. All stages of this disease may mimic tuberculosis.
Laboratory diagnosis:
Clinical material:
Skin scrapings, sputum and bronchial washings, cerebrospinal fluid, pleural fluid and blood, bone marrow, urine and tissue biopsies from various visceral organs.
Tissue morphology of H. capsulatum var. capsulatum (left) showing numerous small narrow base budding yeast cells (1-5um diam) inside macrophages and H. capsulatum var. duboisii (right) showing larger sized budding yeast cells (5-12 um in diam).
Direct microscopy:
(a) Skin scrapings should be examined using 10% KOH and Parker ink or calcofluor white mounts; (b) Exudates and body fluids should be centrifuged and the sediment examined using either 10% KOH and Parker ink or calcofluor white mounts, (c) Tissue sections should be stained using PAS digest, Grocott's methenamine silver (GMS) or Gram stain.Histopathology is especially useful and is one of the most important ways of alerting the laboratory that they may be dealing with a potential pathogen.
Interpretation:
As a rule, a positive direct microscopy demonstrating characteristic yeast-like cells from any specimen should be considered significant.
Culture of Histoplasma capsulatum showing growth as a mould at 25C and as a yeast at 37C.
Culture:
Clinical specimens should be inoculated onto primary isolation media, like Sabouraud's dextrose agar and Brain heart infusion agar supplemented with 5% sheep blood.Interpretation:
A positive culture from any of the above specimens should be considered significant.WARNING:
Cultures of H. capsulatum represent a severe biohazard to laboratory personnel and must be handled with extreme caution in an appropriate pathogen handling cabinet.Serology:
Immunodiffusion and/or complement fixation tests for the detection of antibody have proven to be useful in the diagnosis of Histoplasmosis, especially in immunocompetent patients. However, detection of antibodies in immunosuppressed patients is often difficult, with between 20-50% of patients testing negative.Identification:
Three varieties of Histoplasma capsulatum are recognised, depending on the clinical disease: var. capsulatum is the common cause of histoplasmosis; var. duboisii is the African type and var. farciminosum causes lymphangitis in horses. Histoplasma isolates may also resemble species of Sepedonium and Chrysosporium. Traditionally, positive identification required conversion of the mould form to the yeast phase by growth at 37C on enriched media, however for laboratory safety, culture identification by either exoantigen test or DNA sequencing is now preferred.Causative agents:
Histoplasma capsulatumFurther reading:
Ajello L and R.J. Hay. 1997. Medical Mycology Vol 4 Topley & Wilson's Microbiology and Infectious Infections. 9th Edition, Arnold London.
Chandler FW., W. Kaplan and L. Ajello. 1980. A colour atlas and textbook of the histopathology of mycotic diseases. Wolfe Medical Publications Ltd. London.
Kwon-Chung KJ and JE Bennett 1992. Medical Mycology Lea & Febiger.
Richardson MD and DW Warnock. 1993. Fungal Infection: Diagnosis and Management. Blackwell Scientific Publications, London.
Rippon JW. 1988. Medical Mycology WB Saunders Co. -
Paracoccidioidomycosis
Paracoccidioidomycosis is a chronic granulomatous disease that characteristically produces a primary pulmonary infection, often inapparent, and then disseminates to form ulcerative granulomata of the buccal, nasal and occasionally the gastrointestinal mucosa. The disease in its inception and development is similar to blastomycosis and coccidioidomycosis. The only etiological agent, Paracoccidioides brasiliensis is geographically restricted to areas of South and Central America.
Clinical manifestations:
Clinical manifestions vary from subclinical infections that are detected only by skin-test positivity; to chronic unifocal infection where only a single organ is involved; to chronic multifocal infection where more than one organ is involved. A subacute juvenile infection is also recognised.
Pulmonary paracoccidioidomycosis:
Most cases have an indolent onset and patients present with chronic symptoms such as cough, fever, night sweats, malaise and weight loss. Chest x-rays are characteristic but not diagnostic. The infection must be distinguished from histoplasmosis and tuberculosis.
Mucocutaneous paracoccidioidomycosis showing extensive destruction of facial features and an ulcerated lesion on the pharyngeal mucosa (Courtesy of John Rippon, USA).
Mucocutaneous paracoccidioidomycosis:
The mouth and nose are the most usual mucosal sites of infection. Painful ulcerated lesions develop on the gums, tongue, lips or palate and can progress over weeks or months. Perforation of the palate or nasal septum may occur. Cutaneous lesions often appear on the face around the mouth and nose, although patient with severe infection can have widespread lesions.
Lymphonodular paracoccidioidomycosis:
Lymphadenitis is common in younger patients. Cervical and submandibular chains are the most obvious manifestation and lymph nodes may progress to form abscesses with draining sinuses.Disseminated paracoccidioidomycosis:
Haematogenous spread of P. brasiliensis can resulkt in widespread disseminated disease; including lesions of the small or large intestine, hepatic lesions, adrenal gland destruction, osteomyelitis, arthritis, endophthalmitis and meningoencephalitis or focal cerebral lesions.Laboratory diagnosis:
Clinical material:
Skin scrapings, sputum and bronchial washings, cerebrospinal fluid, pleural fluid and blood, bone marrow, and tissue biopsies from various visceral organs.
Multiple, narrow base, budding yeast cells (steering wheels) of P. brasiliensis. GMS stained lung section (left) and phase contrast of cells from a culture (right).
Direct microscopy:
(a) Skin scrapings should be examined using 10% KOH and Parker ink or calcofluor white mounts; (b) Exudates and body fluids should be centrifuged and the sediment examined using either 10% KOH and Parker ink or calcofluor white mounts, (c) Tissue sections should be stained using PAS digest, Grocott's methenamine silver (GMS) or Gram stain.Histopathology is especially useful and is one of the most important ways of alerting the laboratory that they may be dealing with a potential pathogen.
Interpretation:
As a rule, a positive direct microscopy demonstrating the presence of large, 20-60 um, round, narrow base budding yeast cells with multiple budding "steering wheels" from any specimen should be considered significant.Culture:
Clinical specimens should be inoculated onto primary isolation media, like Sabouraud's dextrose agar and Brain heart infusion agar supplemented with 5% sheep blood.Interpretation:
A positive culture from any of the above specimens should be considered significant.Identification:
Clinical history, tissue pathology, culture identification with conversion to the yeast phase at 37C are important characters.Causative agents:
Paracoccidioides brasiliensisFurther reading:
Ajello L and R.J. Hay. 1997. Medical Mycology Vol 4 Topley & Wilson's Microbiology and Infectious Infections. 9th Edition, Arnold London.
Kwon-Chung KJ and JE Bennett 1992. Medical Mycology Lea & Febiger.
Richardson MD and DW Warnock. 1993. Fungal Infection: Diagnosis and Management. Blackwell Scientific Publications, London.
Rippon JW. 1988. Medical Mycology WB Saunders Co. -
Talaromyces marneffei infection
Talaromyces marneffei exhibits thermal dimorphism by growing in living tissue or in culture at 37C as a yeast-like fungus or in culture at temperatures below 30C as a mould. It has a propensity to cause disease in the normal host, as well as in immunosuppressed patients, but significantly, it has now become a major opportunistic pathogen in HIV positive patients in Indochina. Over 300 cases have been reported with the majority of these coming from Chiang Mai in northern Thailand. Other predisposing factors include lymphoproliferative disorders, bronchiectasis and tuberculosis, autoimmune diseases and corticosteroid therapy. To date, all naturally occurring infections have been in residents of, or travellers to, southeast Asia; especially northern Thailand, Vietnam, Hong Kong, Taiwan and southern China. Imported cases of P. marneffei infections have been reported from Australia, France, Italy, Netherlands, UK and USA.
Clinical manifestations:
In patients with normal immunity, T. marneffei infection may either be disseminated or focal. In the latter, both clinical and histological appearances may strongly resemble tuberculosis (eg. suppurative lymphadenopathy). In HIV patients, T. marneffei infection is usually disseminated at diagnosis. Commonly the skin, reticuloendothelial system, lung and gut are infected. Fungaemia is present in the majority of cases and other organ systems including kidney, bones, joints and pericardium may also be involved. Patients usually present with non-specific symptoms of fever, anaemia and weight loss. Skin lesions are most commonly papules often with a central necrotic umbilication similar in appearance to those seen in molluscum contagiosum and are usually located on the face, trunk and extremities. In many cases numerous subcutaneous abscesses ulcerate over time. It is important to note that the clinical symptoms of disseminated infection by T. marneffei mimic those seen in AIDS patients with disseminated cryptococcal infection or disseminated histoplasmosis.
Click images below to expand:
Finally, little is known about the ecology, epidemiology or pathogenesis of T. marneffei infection. Although bamboo rats are known to be asymptomatic carriers of the fungus, it is unclear whether they are an important reservoir for human infection or only a sentinel animal that is susceptible to infection from an environmental source. Human infections have been reported following traumatic implantation, enteric spread following the eating of bamboo rats as "game cuisine" and by inhalation of spores from soil or possibly a specific host plant. T. marneffei has been isolated from bamboo rat burrows and the current consensus would favour soil as the most likely reservoir with transmission to humans via the respiratory route, similar to that seen with other dimorphic fungi. However this remains to be proven and for now the natural habitat of the fungus and an explanation for its geographic restriction remain unknown.
Laboratory diagnosis:
Clinical material:
Talaromyces marneffei is the only dimorphic member of the genus Talaromyces and is readily detected by direct microscopy and culture of infected tissues, especially skin lesions, bone marrow, blood and lymph nodes.
A Giemsa stained touch smear (left) and a GMS stained tissue section (right) showing typical septate yeast-like cells of T. marneffei. In the latter preparation the cells closely resemble those seen in histoplasmosis
Direct microscopy:
A Giemsa stained touch smear of a skin biopsy or bone marrow aspirate is a rapid and sensitive diagnostic method that readily demonstrates the presence of typical yeast-like cells with a central septa, either within histiocytes or scattered through the tissue. The yeast-cells are spherical to ellipsoidal, 2 to 6 um in diameter, and divide by fission rather than budding, a characteristic visible on stained touch smears that distinguishes T. marneffei from Histoplasma capsulatum.
Tissue sections show small, oval to elliptical yeast-like cells, 3um in diameter, either packed within histiocytes or scattered through the tissue. Occasional, large, elongated sausage shaped cells, up to 8 um long, with distinctive septa may be present. Note: tissue sections need to be stained by Grocott's methenamine silver method to clearly see the yeast-like cells, which are often difficult to observe in H&E preparations.
Culture showing a typical yellow-pink colony with distinctive red diffusable pigment of Talaromyces marneffei.
Culture:
Clinical specimens should be inoculated onto primary isolation media, like Sabouraud's dextrose agar.Serology:
There are currently no commercially available serological procedures for the diagnosis of Talaromyces marneffei infection.Identification:
Clinical history, tissue morphology and culture identification.Causative agents:
Talaromyces marneffeiFurther reading:
Ajello L and R.J. Hay. 1997. Medical Mycology Vol 4 Topley & Wilson's Microbiology and Infectious Infections. 9th Edition, Arnold London.
Kwon-Chung KJ and JE Bennett 1992. Medical Mycology Lea & Febiger.
Vanittanakom N and T. Sirisanthana. 1997. Penicillium marmeffei infection in patients infected with Human Immunodeficiency Virus. Current Topics in Medical Mycology 8:35-42.